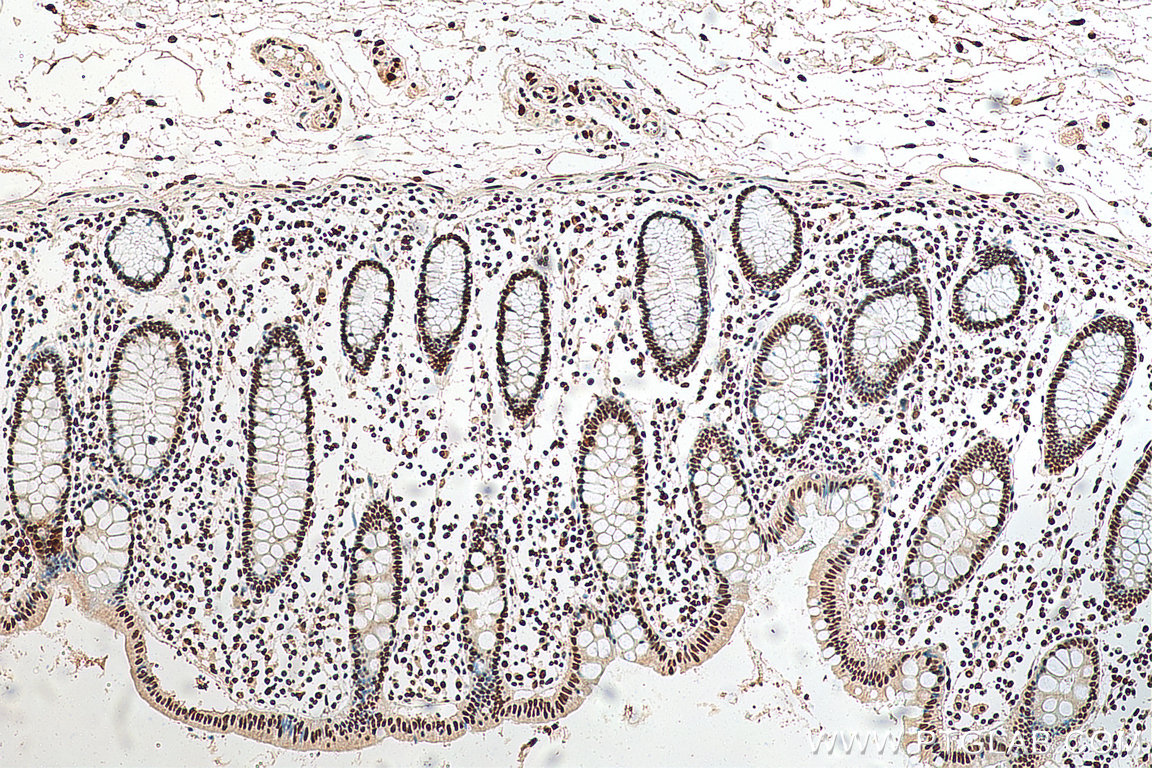
HNRNPA1 Antibody 678441Ig Proteintech
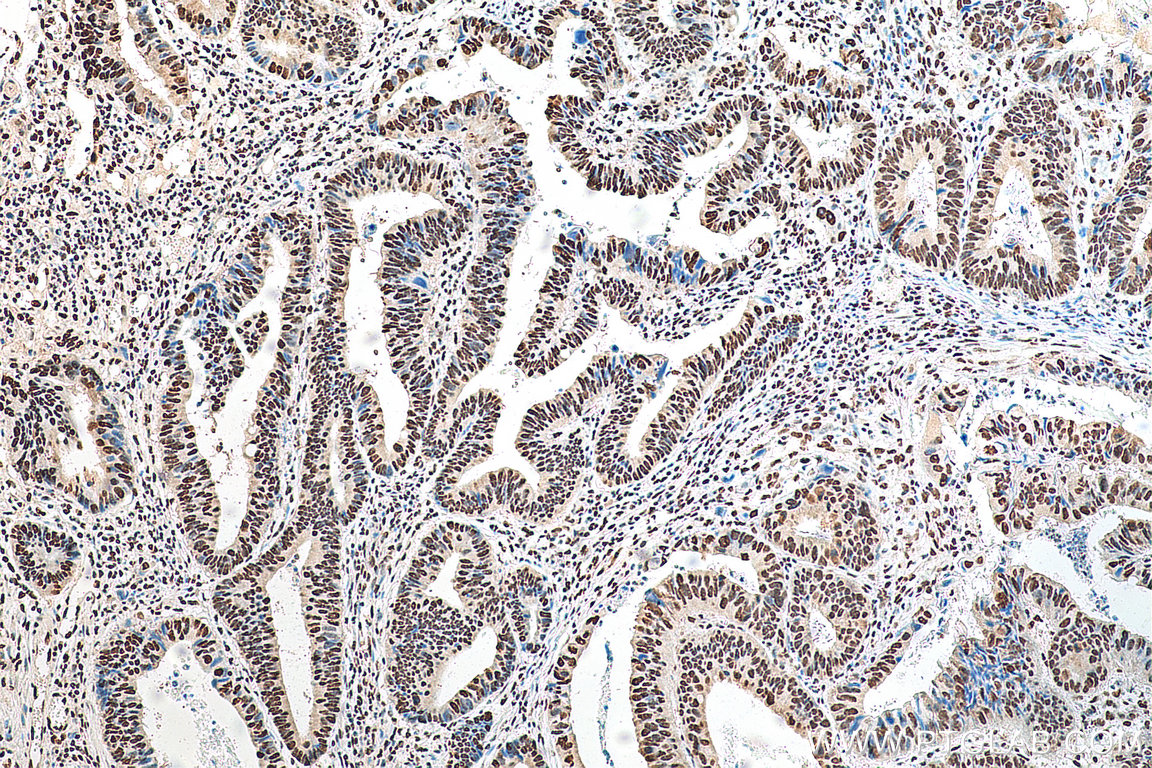
HNRNPA1 Antibody 678441Ig Proteintech

HNRNPA1(heterogeneous nuclear ribonucleoprotein A1、hnRNP A1)は、ヒトではHNRNPA1遺伝子にコードされるタンパク質である。hnRNP A1の変異は、筋萎縮性側索硬化症や多系統蛋白質症の原因となる。
機能
hnRNP A1は、普遍的に発現しているヘテロ核リボヌクレオタンパク質(hnRNP)のA/Bサブファミリーに属する。hnRNPはRNA結合タンパク質であり、ヘテロ核RNA(hnRNA)と複合体を形成する。これらのタンパク質は核内でpre-mRNAと結合し、pre-mRNAのプロセシングやmRNA代謝・輸送の他の側面に影響を及ぼしているようである。hnRNPは全て核内に存在するが、一部は核と細胞質の間を移行しているようである。hnRNPには明確な核酸結合特性がみられる。HNRNPA1遺伝子にコードされるhnRNP A1は、N末端ドメインに2つのquasi-RRMリピートを持ち、これらはRNAへの結合と特異性に重要である。hnRNP A1にはRGGボックスと呼ばれるグリシンに富む領域も存在し、これもRNAへの結合を可能にしている。hnRNP A1は、転写、転写後、翻訳、翻訳後段階で代謝経路を制御している重要な遺伝子の多くに影響を及ぼす。hnRNP A1はhnRNP複合体のコアタンパク質の中で最も豊富に存在するものの中の1つであり、核質に局在する。このタンパク質は他のhnRNPとともに、おそらくmRNAに結合した形で核外へ搬出され、すぐに核内へ再移行する。RGGボックスの下流のグリシンに富む領域に位置するM9核局在化配列は、核局在と核外搬出の双方のシグナルとして作用する。hnRNP A1はpre-mRNAからhnRNP粒子へのパッケージングや核から細胞質へのポリアデニル化mRNAの輸送に関与しており、またスプライシング部位の選択を調節している可能性がある。HNRNPA1遺伝子には複数の選択的スプライシング転写産物が見つかっており、複数の転写開始部位やポリアデニル化部位が存在する。
翻訳後修飾がhnRNP A1の機能に影響を及ぼすことが知られている。RGGボックスのアルギニン残基のメチル化はRNA結合活性を調節している可能性がある。PKC、MAPK、S6KなどのキナーゼはN末端とC末端のセリン残基をリン酸化し、その機能を調節する。C末端領域のリン酸化はhnRNP A1の細胞質への蓄積を引き起こす。セリンもしくはスレオニン残基に対して行われるO-GlcNAc化は広くみられる可逆的修飾であり、カリオフェリンβ(トランスポーチン1)への結合を妨げ、hnRNP A1の核局在を引き起こす。
相互作用
hnRNP A1は、BAT2、FEN1、IκBαと相互作用することが示されている。
ウイルス複製における役割
hnRNP A1は、感染後に複数のステージが存在するDNAウイルス、+鎖RNAウイルス、-鎖RNAウイルスの生活環に関与している。ウイルスの生活環におけるこのタンパク質の役割はウイルスごとに異なり、相反する役割を果たしている場合もある。hnRNP A1は一部のウイルスではウイルスの複製を促進し、他のウイルスでは阻害する役割を果たす。
hnRNP A1の抗ウイルス作用は、HTLV-1細胞培養モデルで観察される。hnRNP A1は、ウイルスRNAの3' LTRに存在する応答エレメントに対するRexタンパク質の結合を阻害する。hnRNP A1の異所性発現はRexと競合することでその転写後活性に対抗し、ウイルス複製に負の影響を及ぼしてHTLV-1の感染に対する抗ウイルス効果を示す。+鎖RNAウイルスであるC型肝炎ウイルス(HCV)の場合、hnRNP A1は"cis-acting replication element"と呼ばれる、ウイルスのORFの3'末端付近に存在する重要な領域と相互作用する。hnRNP A1がアップレギュレーションされている場合にはHCVの複製は低下し、ダウンレギュレーションされている場合には増加する。
hnRNP A1のウイルスに対する促進作用は、シンドビスウイルス(+鎖RNAウイルス)感染モデルで観察される。hnRNP A1はウイルスRNAの5' UTRに結合し、ウイルス複製が行われる細胞質部位へ再分布して-鎖RNAの合成を促進する。hnRNP A1はブタ流行性下痢ウイルス(PEDV)の感染時にも同様の役割を果たしており、hnRNP A1はPEDVのヌクレオカプシドタンパク質と共免疫沈降される。hnRNP A1はウイルスの効率的な複製に重要な、末端のリーダー配列や遺伝子間配列にも結合する。同様の傾向はライノウイルス(HRV)、エンテロウイルス71(EV-71)、トリレオウイルス(ARV)の感染時にも観察される。
HIV-1など一部のウイルスでは、研究によって相反する結果が得られている。ある研究では、HIV-1の感染後にhnRNP A1は内因性発現が増加ており、またhnRNP A1のダウンレギュレーションがウイルス複製に影響を及ぼすことから、hnRNP Aの発現上昇はウイルスに好都合となることが報告されている。一方で他の研究では、in vitroでのhnRNP A1の過剰発現がウイルス複製に悪影響を与えることが報告されている。このように、HIV-1の生活環におけるhnRNP A1の役割には議論がある。
その他の疾患における役割
hnRNP A1の変異は筋萎縮性側索硬化症や多系統蛋白質症の原因となる。
hnRNP A1はOct-4やサーチュイン1のmRNAを安定化し、細胞老化や細胞老化随伴分泌現象の誘導に対抗する。
出典
関連文献